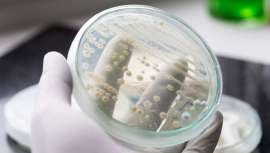
La Clínica Omega Zeta presenta sus tratamientos de micoterapia, basados en el uso de las setas, que previenen y tratan enfermedades, caso de procesos oncológicos con hongos o autoinmunes, entre otras, con hongos medicinales

-
Cómo abordar el gran dilema de la peluquería
-
Balayage caramelo, la opción para morenas que les hace brillar
Se trata de un tono ideal para las mujeres castañas y morenas que desean sublimar su bonito bronceado o piel morena en cualquier época del año. Esta temporada, el 'balayage' caramelo es ideal en melenas cortas, 'midi', largas o extralargas
-
Recogidos para pelo rizado que funcionan (y favorecen) en cualquier ocasión
Descubre cómo son los recogidos que se llevan en cabellos rizados esta temporada, según los expertos de Llongueras
-
Los degradados y texturizados, entre las próximas tendencias en cortes para hombre
Los cortes 'slicked back', los flequillos texturizados y el estilo 'mod' marcarán las tendencias masculinas de 2026 junto a los 'mid' y 'high fade', con claves de mantenimiento en casa de la mano de expertos del sector profesional
-
El peinado de novia se convierte en una obra de arte
La colección art gallery, creada por juanmy medialdea, transforma la peluquería nupcial en una auténtica exposición artística
-
Nombres de peluquerías originales
Un negocio suele comenzar con una buena idea. Además de hacer un concienzudo plan de empresa también hay que buscar un nombre original, único y moderno que haga funcionar a nuestra peluquería
-
CONCURSO BEAUTY MARKET PELUQUERÍA
Conviértete en patrocinador del concurso que conecta tu marca con los profesionales de la imagen personal
Una oportunidad estratégica para posicionar tus productos directamente en manos de estilistas, barberos, esteticistas y especialistas del sector